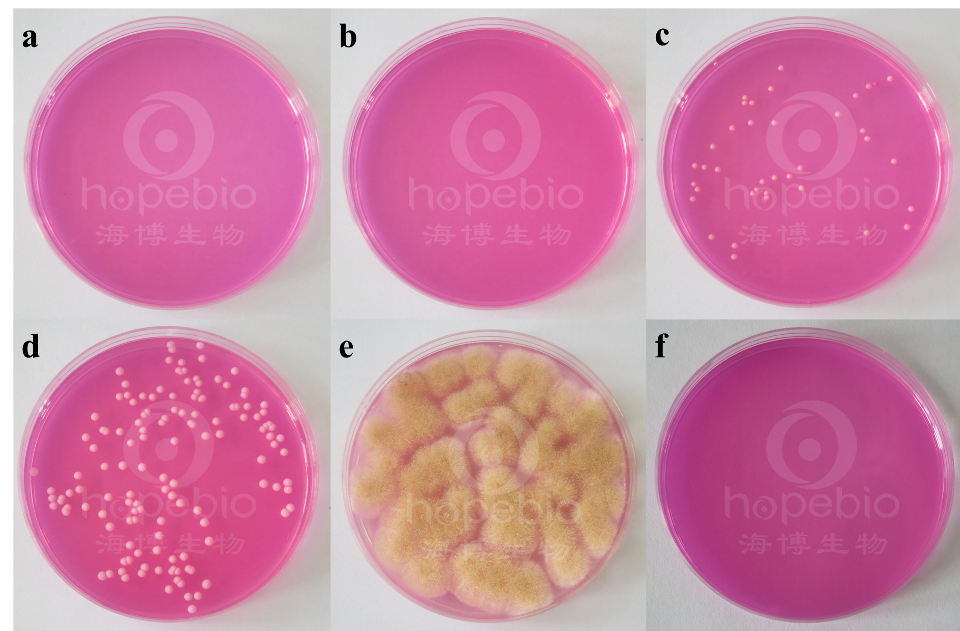

海博微信公众号
海博微信公众号
 海博天猫旗舰店
海博天猫旗舰店


 海博微信公众号
海博微信公众号
 海博天猫旗舰店
海博天猫旗舰店




用途:用于食品中霉菌及酵母菌总数测定(GB/T4789.15-2010,GB4789.28-2013和化妆品卫生规范微生物检验方法2007版)。
原理:蛋白胨提供碳源和氮源;葡萄糖提供能源;磷酸二氢钾为缓冲剂;硫酸镁提供必须的微量元素;琼脂是培养基的凝固剂;氯霉素可抑制细菌的生长;孟加拉红作为选择性抑菌剂可抑制细菌的生长,并可减缓某些霉菌因生长过快而导致菌落漫延生长。
操作步骤:
使用前,把制备好的平板放置室温10-20分钟。
1、制备质控菌液。
2、选择合适稀释度的目标菌质控菌液0.1ml,均匀涂布于平板上,每一稀释度接种两个平板。
3、用1μL接种环取非目标菌质控菌液1环,将接种环接触容器边缘3次去除多余液体,在平板表面划六条平行直线,同时接种两个平板。
4、28±1℃倒置培养基培养5d,记录实验结果。
微生物试验:
接种以下质控菌株,28±1℃倒置培养基培养5d:

方法的局限性
本培养基仅为细菌鉴定的一部分,需做其他补充试验。
孟加拉红培养基微生物质控结果
a:金黄色葡萄球菌,b:大肠埃希氏菌,c:酿酒酵母,d:白色念珠菌,e:黑曲霉,f:空白对照
相关产品:
注:本文属海博生物原创,未经允许不得转载。
上一篇:粘液酸盐培养基原理及应用



